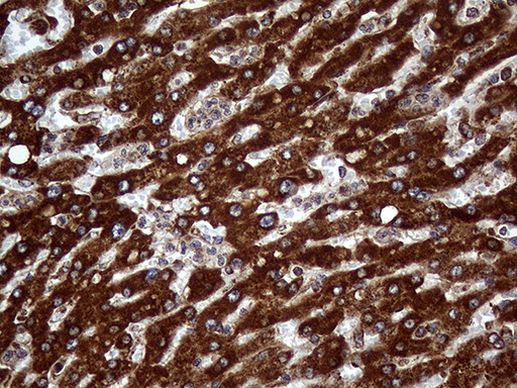
PPIF Antibody in Immunohistochemistry (Paraffin) (IHC (P))

Search
OriGene
PPIF Monoclonal Antibody (OTI7D12), TrueMAB™
{{$productOrderCtrl.translations['antibody.pdp.commerceCard.promotion.promotions']}}
{{$productOrderCtrl.translations['antibody.pdp.commerceCard.promotion.viewpromo']}}
{{$productOrderCtrl.translations['antibody.pdp.commerceCard.promotion.promocode']}}: {{promo.promoCode}} {{promo.promoTitle}} {{promo.promoDescription}}. {{$productOrderCtrl.translations['antibody.pdp.commerceCard.promotion.learnmore']}}
产品信息
TA809030
种属反应
宿主/亚型
分类
类型
克隆号
抗原
偶联物
形式
浓度
纯化类型
保存液
内含物
保存条件
运输条件
靶标信息
The protein encoded by this gene is a member of the peptidyl-prolyl cis-trans isomerase (PPIase) family. PPIases catalyze the cis-trans isomerization of proline imidic peptide bonds in oligopeptides and accelerate the folding of proteins. This protein is part of the mitochondrial permeability transition pore in the inner mitochondrial membrane. Activation of this pore is thought to be involved in the induction of apoptotic and necrotic cell death.
仅用于科研。不用于诊断过程。未经明确授权不得转售。
篇参考文献 (0)
生物信息学
蛋白别名: cyclophilin 3; Cyclophilin D; Cyclophilin F; CyP-D; CyP-M; Mitochondrial cyclophilin; mitochondrial peptidyl-prolyl cis-trans isomerase; Peptidyl-prolyl cis-trans isomerase F; Peptidyl-prolyl cis-trans isomerase F, mitochondrial; peptidyl-prolyl cis-trans isomerase, mitochondrial; PPIase F; Rotamase F
基因别名: Cyp-D; CyP-M; CYP3; CypD; PPIF
UniProt ID: (Human) P30405
Entrez Gene ID: (Human) 10105